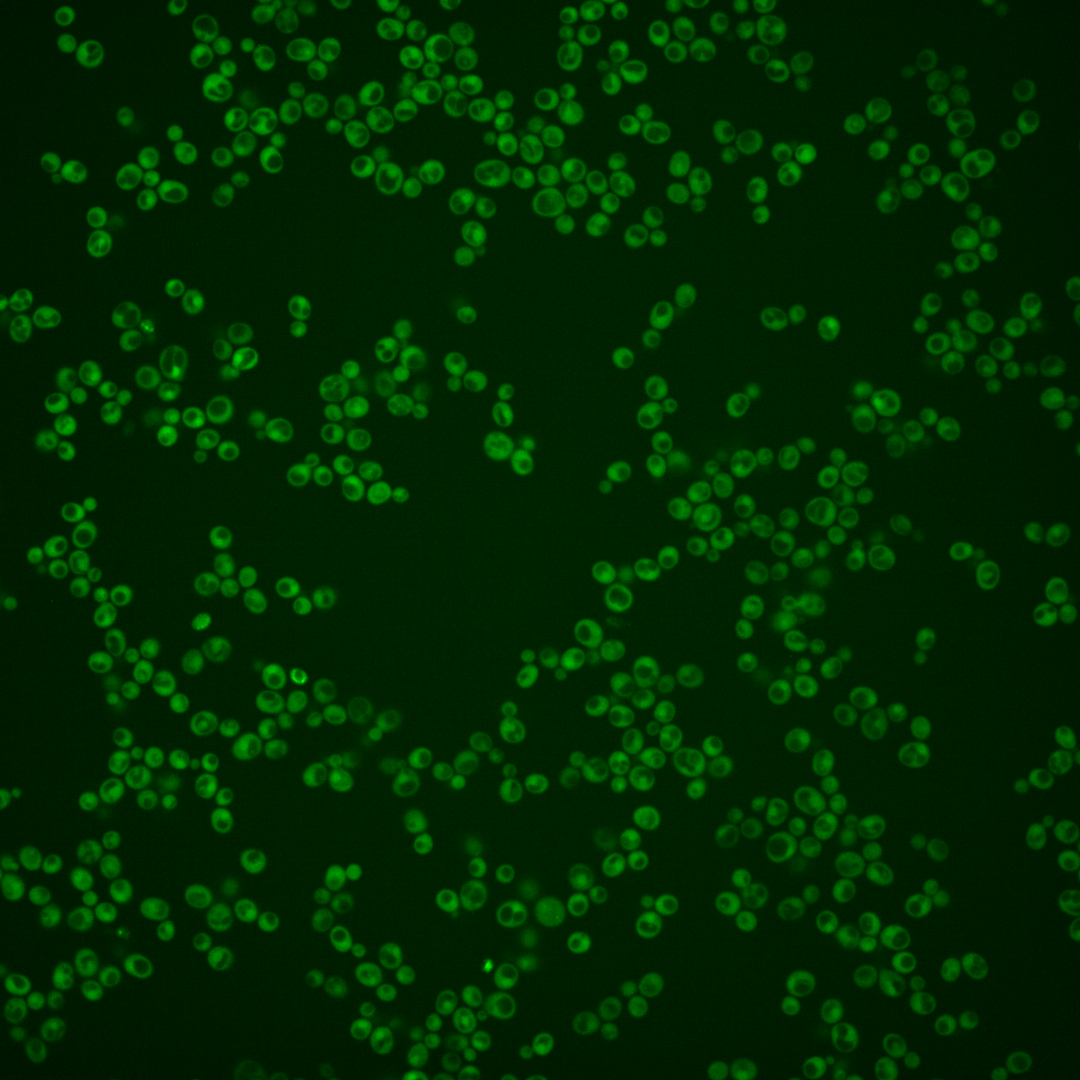
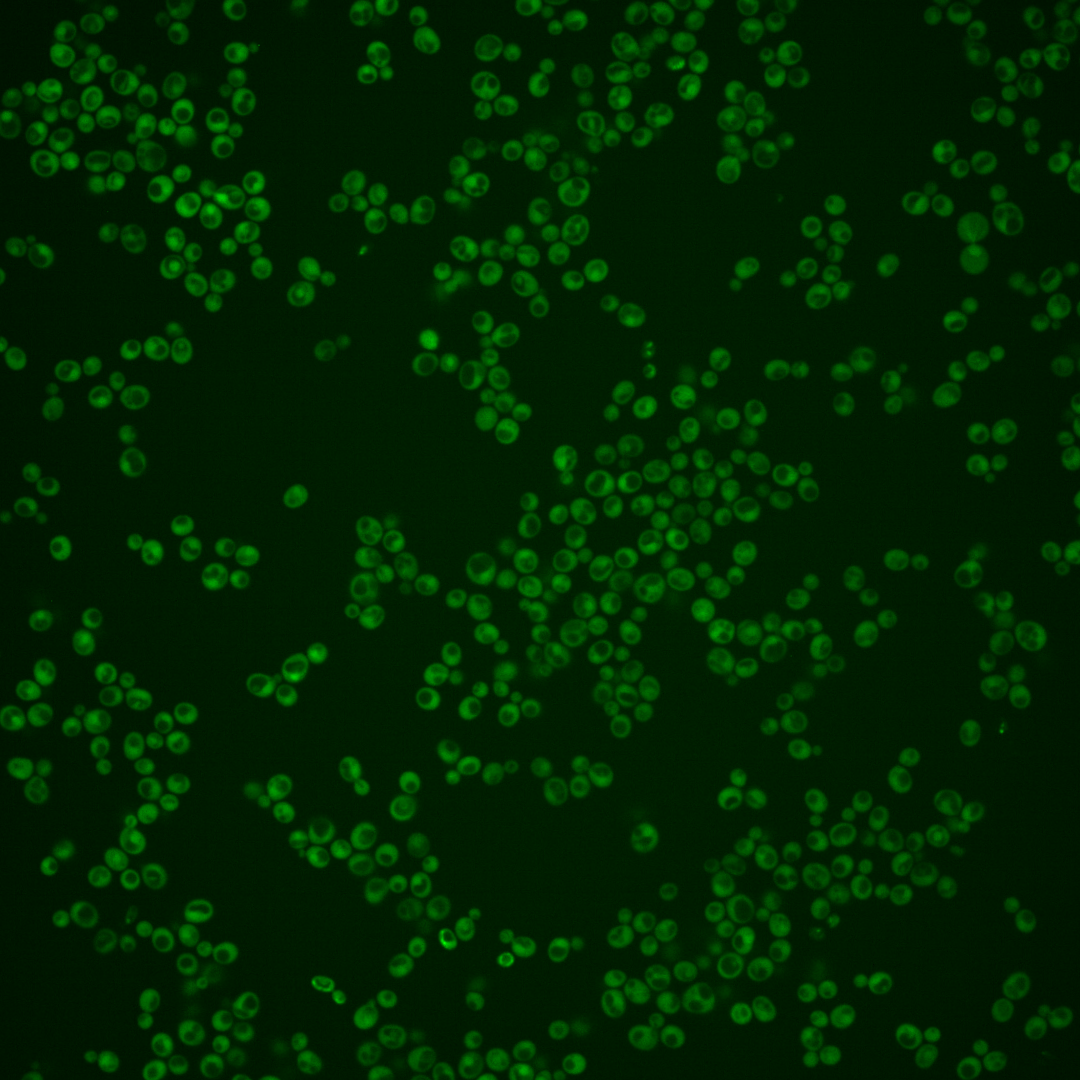
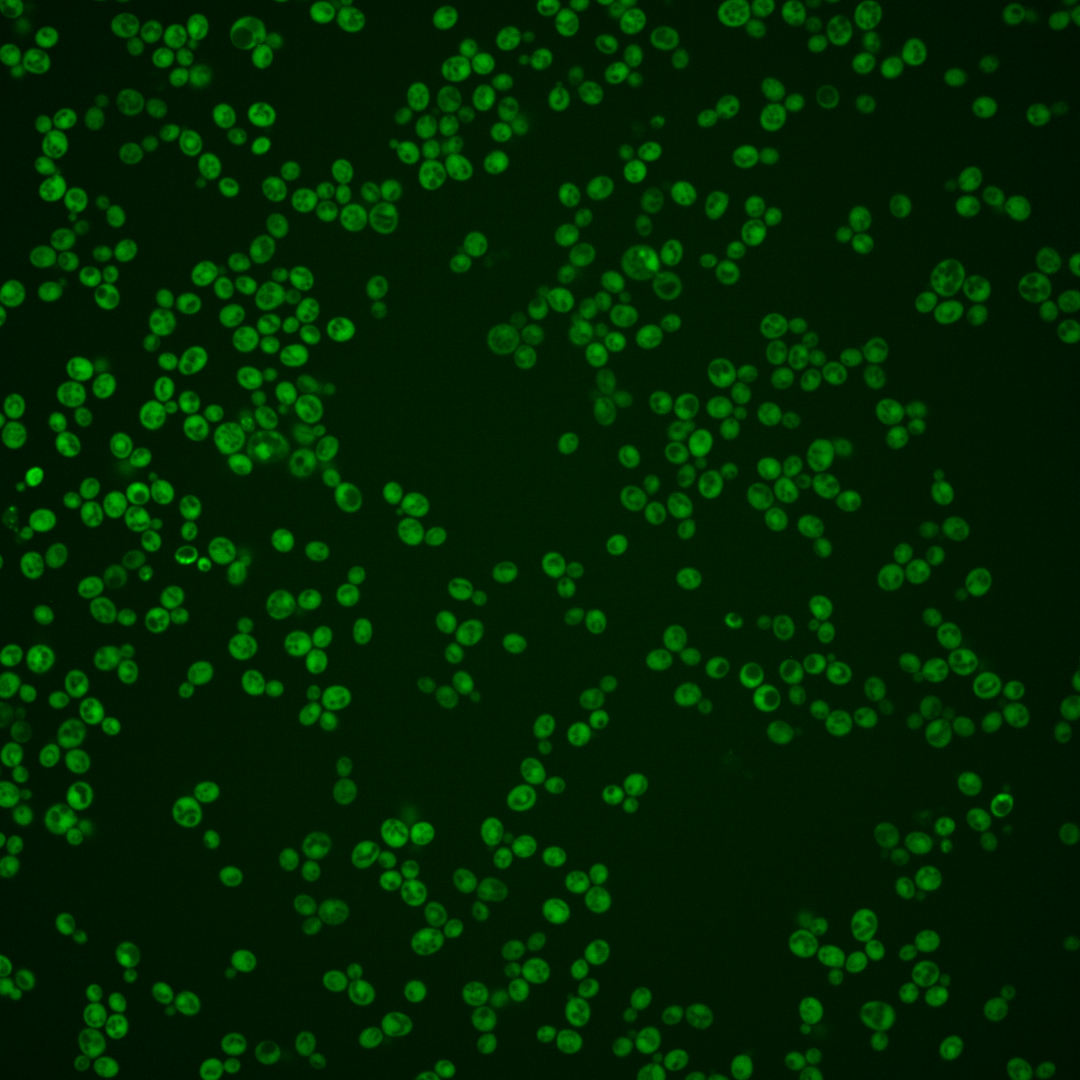
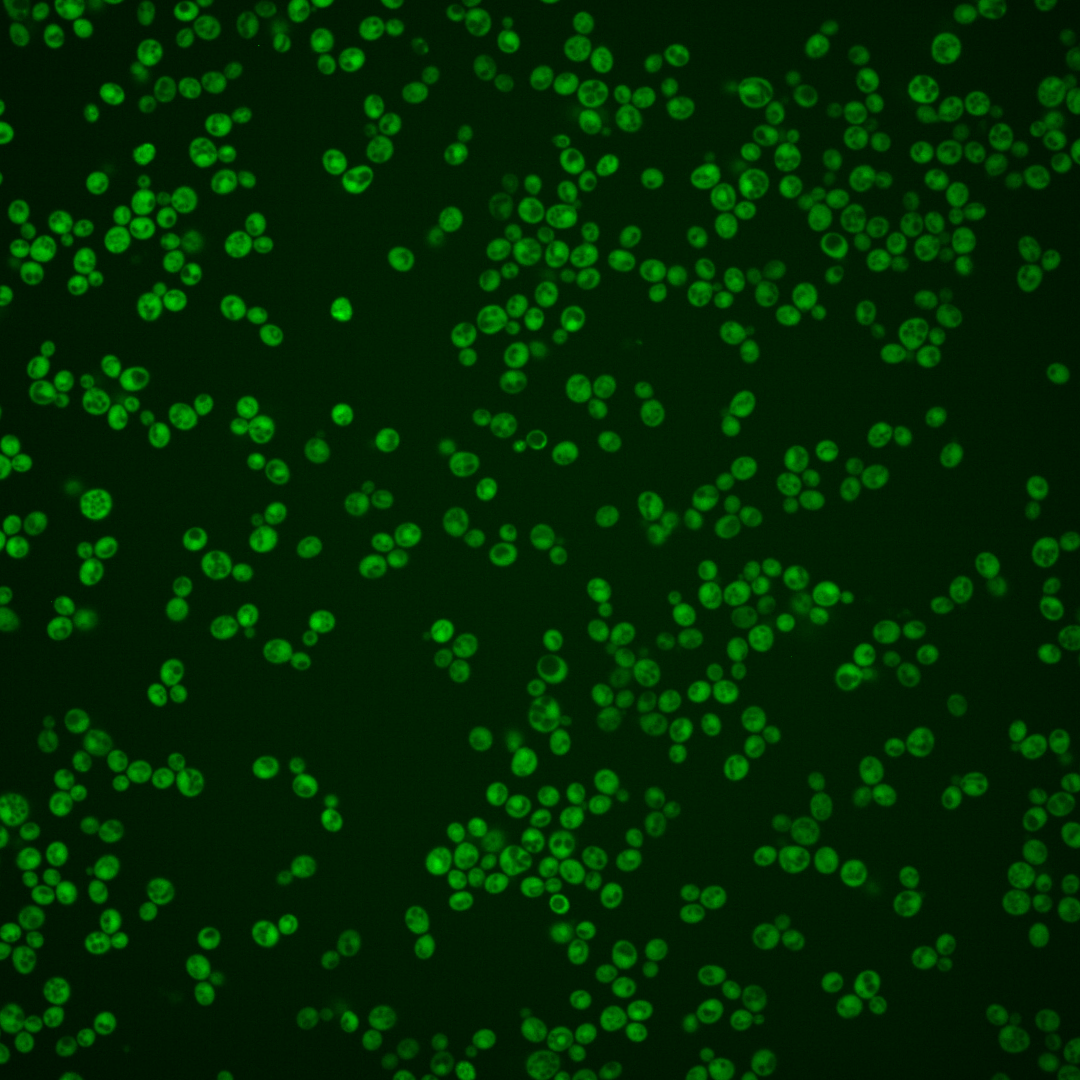
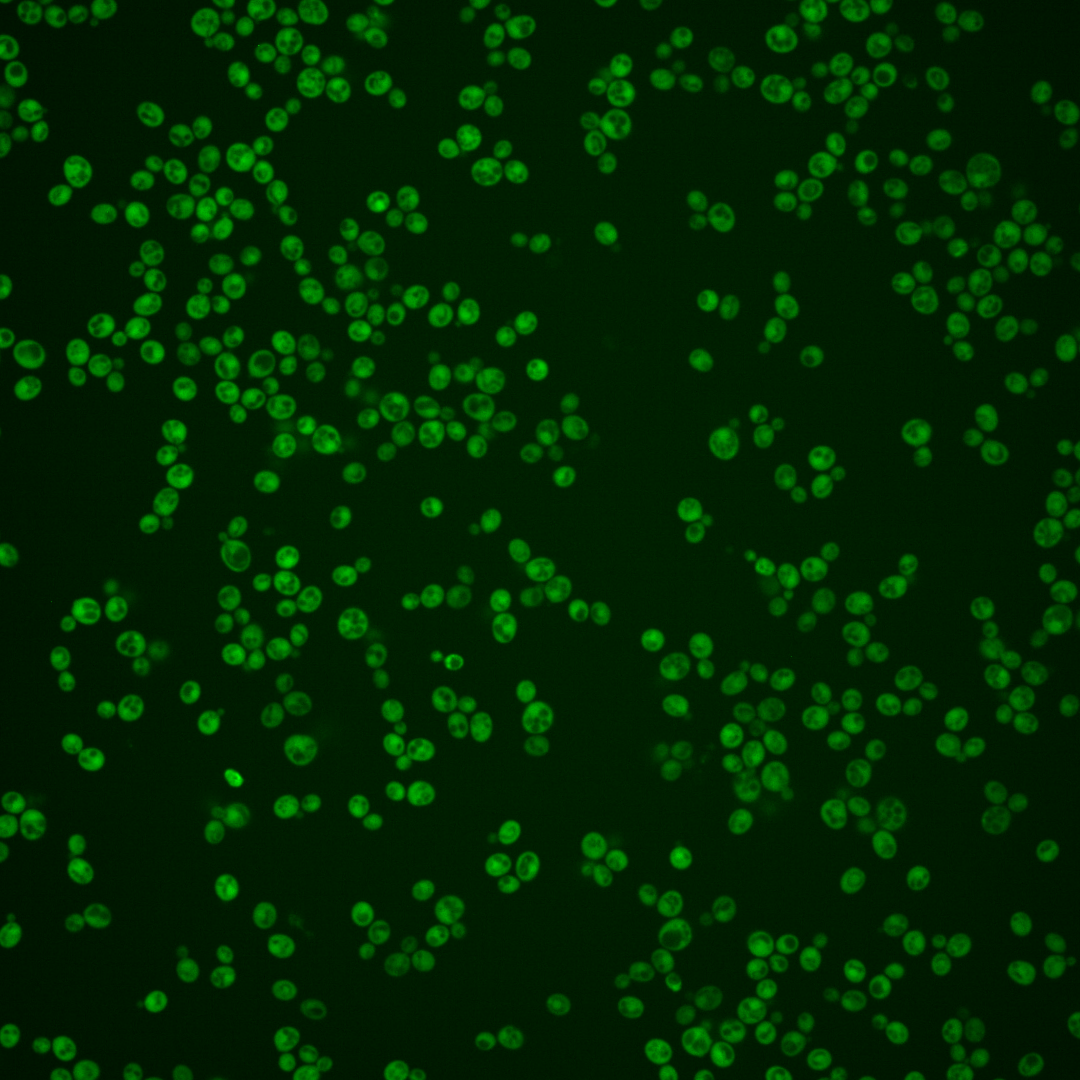
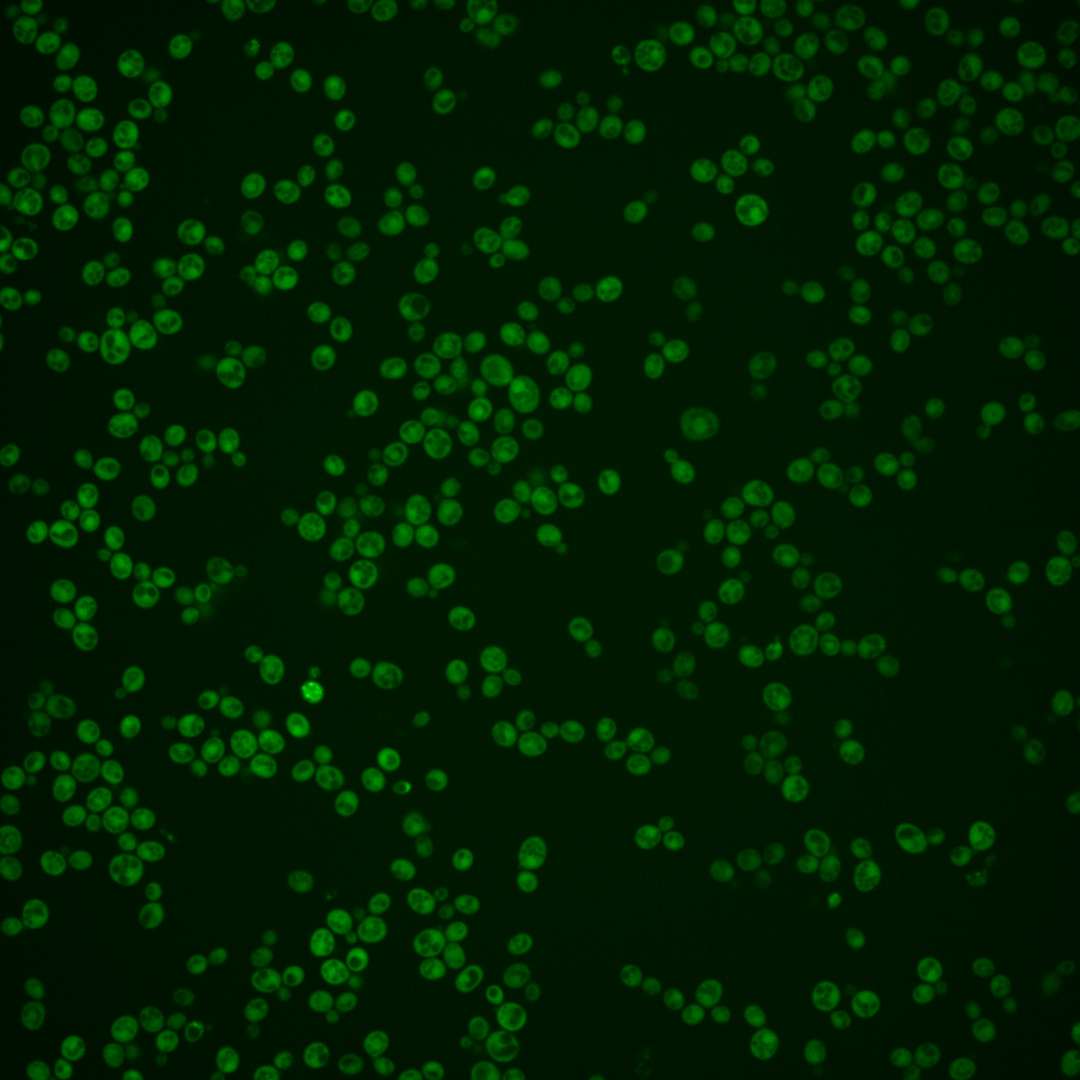

| Standard name | |
|---|---|
| Human Ortholog | |
| Description | Ferulic acid decarboxylase; involved in the decarboxylation of aromatic carboxylic acids such as phenylacrylic (cinnamic) acid, ferulic acid and coumaric acid and formation of the corresponding vinyl derivatives; overexpression of both Pad1p and Fdc1p increases decarboxylase activity due to the Pad1p-catalyzed formation of a diffusible cofactor required for Fdc1p activity; homolog of E. coli UbiD; GFP-fusion protein localizes to the cytoplasm in an HTP study |
Micrographs




















































































Sub-cellular Localization
Yeast GFP Assignment
Protein Abundance
Localization Change
External localization resources
| ensLOC | DeepLoc | |||||||||||||||||||||||
|---|---|---|---|---|---|---|---|---|---|---|---|---|---|---|---|---|---|---|---|---|---|---|---|---|
| Localization | WT1 | WT2 | WT3 | RAP60 | RAP140 | RAP220 | RAP300 | RAP380 | RAP460 | RAP540 | RAP620 | RAP700 | HU80 | HU120 | HU160 | rpd3Δ_1 | rpd3Δ_2 | rpd3Δ_3 | WT1 | WT2 | WT3 | AF100 | AF140 | AF180 |
| Cortical Patches | 0 | 0 | 0 | 0 | 0 | 0 | 0 | 1 | 1 | 1 | 0 | 0 | 0 | 1 | 0 | – | – | – | 1 | 1 | 1 | 0 | 1 | 1 |
| Bud | 0 | 4 | 0 | 0 | 0 | 0 | 3 | 4 | 3 | 5 | 3 | 3 | 1 | 1 | 0 | – | – | – | 3 | 16 | 3 | 0 | 3 | 15 |
| Bud Neck | 0 | 0 | 0 | 0 | 0 | 0 | 0 | 0 | 0 | 1 | 0 | 0 | 0 | 0 | 0 | – | – | – | 0 | 0 | 0 | 0 | 0 | 1 |
| Bud Site | 0 | 0 | 0 | 0 | 0 | 0 | 0 | 1 | 0 | 0 | 1 | 0 | 0 | 0 | 0 | – | – | – | – | – | – | – | – | – |
| Cell Periphery | 0 | 2 | 2 | 0 | 1 | 3 | 4 | 6 | 7 | 5 | 4 | 10 | 1 | 2 | 4 | – | – | – | 0 | 0 | 0 | 0 | 0 | 0 |
| Cytoplasm | 192 | 392 | 219 | 140 | 237 | 323 | 387 | 355 | 291 | 319 | 206 | 197 | 187 | 393 | 471 | – | – | – | 170 | 352 | 206 | 88 | 213 | 229 |
| Endoplasmic Reticulum | 0 | 0 | 2 | 0 | 1 | 1 | 1 | 7 | 12 | 14 | 7 | 0 | 0 | 1 | 2 | – | – | – | 0 | 1 | 4 | 2 | 2 | 4 |
| Endosome | 0 | 0 | 0 | 0 | 0 | 0 | 2 | 2 | 0 | 0 | 0 | 0 | 0 | 2 | 1 | – | – | – | 0 | 4 | 2 | 0 | 0 | 1 |
| Golgi | 0 | 0 | 0 | 0 | 0 | 0 | 0 | 0 | 0 | 0 | 0 | 0 | 0 | 0 | 0 | – | – | – | 0 | 2 | 0 | 0 | 0 | 1 |
| Mitochondria | 8 | 6 | 2 | 4 | 7 | 55 | 79 | 97 | 124 | 187 | 109 | 147 | 1 | 1 | 1 | – | – | – | 2 | 4 | 4 | 0 | 2 | 3 |
| Nucleus | 0 | 2 | 4 | 1 | 0 | 0 | 1 | 9 | 10 | 6 | 4 | 7 | 3 | 1 | 4 | – | – | – | 0 | 0 | 0 | 0 | 0 | 0 |
| Nuclear Periphery | 0 | 0 | 1 | 0 | 0 | 0 | 1 | 1 | 0 | 5 | 3 | 1 | 0 | 0 | 0 | – | – | – | 0 | 0 | 0 | 0 | 1 | 0 |
| Nucleolus | 0 | 0 | 0 | 0 | 0 | 0 | 1 | 1 | 0 | 0 | 0 | 1 | 0 | 0 | 0 | – | – | – | 0 | 0 | 0 | 0 | 0 | 0 |
| Peroxisomes | 0 | 0 | 0 | 0 | 0 | 0 | 0 | 0 | 0 | 0 | 0 | 0 | 0 | 0 | 0 | – | – | – | 0 | 0 | 0 | 0 | 0 | 0 |
| SpindlePole | 0 | 0 | 0 | 0 | 0 | 0 | 2 | 1 | 0 | 1 | 1 | 0 | 0 | 0 | 0 | – | – | – | 1 | 8 | 0 | 0 | 0 | 1 |
| Vac/Vac Membrane | 0 | 2 | 0 | 4 | 9 | 24 | 30 | 36 | 23 | 29 | 24 | 25 | 0 | 3 | 3 | – | – | – | 0 | 6 | 7 | 3 | 6 | 9 |
| Unique Cell Count | 194 | 400 | 226 | 143 | 247 | 367 | 462 | 469 | 404 | 476 | 308 | 318 | 190 | 398 | 480 | 186 | 405 | 238 | 98 | 237 | 277 | |||
| Labelled Cell Count | 200 | 408 | 230 | 149 | 255 | 406 | 511 | 521 | 471 | 573 | 362 | 391 | 193 | 405 | 486 | 186 | 405 | 238 | 98 | 237 | 277 | |||
Yeast GFP Assignment
Protein Abundance
| Screen | WT1 | WT2 | WT3 | RAP60 | RAP140 | RAP220 | RAP300 | RAP380 | RAP460 | RAP540 | RAP620 | RAP700 | HU80 | HU120 | HU160 | rpd3Δ_1 | rpd3Δ_2 | rpd3Δ_3 | AF100 | AF140 | AF180 |
|---|---|---|---|---|---|---|---|---|---|---|---|---|---|---|---|---|---|---|---|---|---|
| Mean Cell GFP Intensity (1e-4) | 5.9 | 7.3 | 7.1 | 7.5 | 7.8 | 6.9 | 6.4 | 6.5 | 6.1 | 5.7 | 5.9 | 5.5 | 8.8 | 9.0 | 8.8 | – | – | – | 7.5 | 8.3 | 9.0 |
| Std Deviation (1e-4) | 2.0 | 2.5 | 2.1 | 2.1 | 2.5 | 2.2 | 2.4 | 2.1 | 2.0 | 2.0 | 2.0 | 2.0 | 2.6 | 2.6 | 2.7 | – | – | – | 2.5 | 2.6 | 2.7 |
| Intensity Change (Log2) | – | – | – | 0.08 | 0.13 | -0.05 | -0.15 | -0.13 | -0.21 | -0.31 | -0.27 | -0.36 | 0.31 | 0.35 | 0.3 | – | – | – | 0.08 | 0.23 | 0.34 |
Localization Change
| Localization | RAP60 | RAP140 | RAP220 | RAP300 | RAP380 | RAP460 | RAP540 | RAP620 | RAP700 | HU80 | HU120 | HU160 | rpd3Δ_1 | rpd3Δ_2 | rpd3Δ_3 |
|---|---|---|---|---|---|---|---|---|---|---|---|---|---|---|---|
| Cortical Patches | 0 | 0 | 0 | 0 | 0 | 0 | 0 | 0 | 0 | 0 | 0 | 0 | – | – | – |
| Bud | 0 | 0 | 0 | 0 | 0 | 0 | 0 | 0 | 0 | 0 | 0 | 0 | – | – | – |
| Bud Neck | 0 | 0 | 0 | 0 | 0 | 0 | 0 | 0 | 0 | 0 | 0 | 0 | – | – | – |
| Bud Site | 0 | 0 | 0 | 0 | 0 | 0 | 0 | 0 | 0 | 0 | 0 | 0 | – | – | – |
| Cell Periphery | 0 | 0 | 0 | 0 | 0 | 0 | 0 | 0 | 0 | 0 | 0 | 0 | – | – | – |
| Cytoplasm | 0.6 | -0.6 | -3.8 | -5.0 | -6.9 | -7.6 | -8.7 | -8.5 | -9.5 | 1.0 | 1.6 | 1.0 | – | – | – |
| Endoplasmic Reticulum | 0 | 0 | 0 | 0 | 0 | 1.7 | 1.7 | 0 | 0 | 0 | 0 | 0 | – | – | – |
| Endosome | 0 | 0 | 0 | 0 | 0 | 0 | 0 | 0 | 0 | 0 | 0 | 0 | – | – | – |
| Golgi | 0 | 0 | 0 | 0 | 0 | 0 | 0 | 0 | 0 | 0 | 0 | 0 | – | – | – |
| Mitochondria | 0 | 0 | 5.7 | 6.2 | 7.0 | 9.0 | 10.7 | 9.7 | 11.7 | 0 | 0 | 0 | – | – | – |
| Nucleus | 0 | 0 | 0 | 0 | 0 | 0.6 | 0 | 0 | 0 | 0 | 0 | 0 | – | – | – |
| Nuclear Periphery | 0 | 0 | 0 | 0 | 0 | 0 | 0 | 0 | 0 | 0 | 0 | 0 | – | – | – |
| Nucleolus | 0 | 0 | 0 | 0 | 0 | 0 | 0 | 0 | 0 | 0 | 0 | 0 | – | – | – |
| Peroxisomes | 0 | 0 | 0 | 0 | 0 | 0 | 0 | 0 | 0 | 0 | 0 | 0 | – | – | – |
| SpindlePole | 0 | 0 | 0 | 0 | 0 | 0 | 0 | 0 | 0 | 0 | 0 | 0 | – | – | – |
| Vacuole | 0 | 0 | 3.9 | 3.9 | 4.3 | 3.7 | 3.8 | 4.3 | 4.3 | 0 | 0 | 0 | – | – | – |
External localization resources
Images






























Protein Concentration and Protein Localization Data
| R1 | R2 | R3 | ||||||||||||||||
|---|---|---|---|---|---|---|---|---|---|---|---|---|---|---|---|---|---|---|
| G1 Pre-START | G1 Post-START | S/G2 | Metaphase | Anaphase | Telophase | G1 Pre-START | G1 Post-START | S/G2 | Metaphase | Anaphase | Telophase | G1 Pre-START | G1 Post-START | S/G2 | Metaphase | Anaphase | Telophase | |
| Concentration | 1.9207 | 2.8818 | 2.1312 | 2.3309 | 1.9098 | 2.2369 | 2.8731 | 4.5713 | 3.105 | 2.6233 | 2.28 | 3.0067 | 4.1595 | 5.5812 | 4.5698 | 5.9661 | 3.985 | 4.8308 |
| Actin | 0.0118 | 0.0005 | 0.0008 | 0.0005 | 0.0001 | 0.002 | 0.0331 | 0.0007 | 0.0076 | 0.0083 | 0.0108 | 0.0175 | 0.0111 | 0.0009 | 0.0298 | 0.0006 | 0.0013 | 0.0163 |
| Bud | 0.0002 | 0.0001 | 0.0019 | 0.0004 | 0 | 0.0002 | 0.0009 | 0.0002 | 0.0015 | 0.0061 | 0.0004 | 0.0026 | 0.0007 | 0.0007 | 0.0008 | 0.0006 | 0.0013 | 0.0005 |
| Bud Neck | 0.0011 | 0.0002 | 0.0029 | 0.0004 | 0.0002 | 0.0011 | 0.0009 | 0.0001 | 0.0002 | 0.0005 | 0.0005 | 0.0013 | 0.0012 | 0.0003 | 0.0034 | 0.0003 | 0.0004 | 0.0008 |
| Bud Periphery | 0.0001 | 0.0001 | 0.0028 | 0.0005 | 0 | 0.0002 | 0.0014 | 0.0002 | 0.0007 | 0.0079 | 0.0004 | 0.0014 | 0.0025 | 0.0004 | 0.0014 | 0.0043 | 0.0049 | 0.0004 |
| Bud Site | 0.0009 | 0.0005 | 0.0051 | 0.0002 | 0 | 0.0001 | 0.0016 | 0.0006 | 0.0061 | 0.0018 | 0.0005 | 0.0003 | 0.0058 | 0.0028 | 0.0009 | 0.0001 | 0.0001 | 0.0005 |
| Cell Periphery | 0.0001 | 0.0002 | 0.0004 | 0.0001 | 0 | 0.0001 | 0.0002 | 0.0001 | 0.0001 | 0.0004 | 0.0001 | 0.0001 | 0.0005 | 0.0001 | 0.0003 | 0.0001 | 0.0002 | 0 |
| Cytoplasm | 0.7092 | 0.7699 | 0.7591 | 0.7797 | 0.6928 | 0.7485 | 0.5234 | 0.715 | 0.5462 | 0.4869 | 0.5699 | 0.5757 | 0.739 | 0.8099 | 0.708 | 0.7607 | 0.6301 | 0.7554 |
| Cytoplasmic Foci | 0.0057 | 0.0056 | 0.0082 | 0.0035 | 0.0036 | 0.0059 | 0.03 | 0.0123 | 0.0056 | 0.008 | 0.0244 | 0.0066 | 0.0267 | 0.0087 | 0.0112 | 0.003 | 0.0042 | 0.0134 |
| Eisosomes | 0.0001 | 0.0003 | 0.0002 | 0 | 0 | 0.0001 | 0.0004 | 0 | 0.0002 | 0.0002 | 0.0001 | 0.0002 | 0.0002 | 0.0001 | 0.0003 | 0.0001 | 0.0001 | 0 |
| Endoplasmic Reticulum | 0.0044 | 0.0089 | 0.0041 | 0.0065 | 0.0039 | 0.0052 | 0.0043 | 0.0015 | 0.0018 | 0.0037 | 0.0025 | 0.0017 | 0.0066 | 0.0028 | 0.0094 | 0.0006 | 0.0023 | 0.0024 |
| Endosome | 0.004 | 0.0026 | 0.0023 | 0.0014 | 0.0013 | 0.0064 | 0.0144 | 0.0018 | 0.0038 | 0.0022 | 0.0031 | 0.0027 | 0.0104 | 0.0012 | 0.0049 | 0.0012 | 0.0008 | 0.0037 |
| Golgi | 0.002 | 0.0005 | 0.0004 | 0.0001 | 0.0001 | 0.0005 | 0.0079 | 0.0003 | 0.0015 | 0.0007 | 0.0024 | 0.0021 | 0.0019 | 0.0002 | 0.0024 | 0.0001 | 0.0001 | 0.0035 |
| Lipid Particles | 0.0019 | 0.0052 | 0.0008 | 0.0002 | 0.0006 | 0.0008 | 0.0061 | 0.0001 | 0.0036 | 0.0208 | 0.0044 | 0.0028 | 0.0032 | 0.0001 | 0.0102 | 0 | 0.0002 | 0.0071 |
| Mitochondria | 0.0003 | 0.0004 | 0.0005 | 0.0003 | 0.0001 | 0.0011 | 0.0072 | 0.0002 | 0.0005 | 0.0017 | 0.0284 | 0.0008 | 0.0006 | 0.0005 | 0.0012 | 0.0006 | 0.0004 | 0.0015 |
| None | 0.2416 | 0.1961 | 0.2028 | 0.1891 | 0.2917 | 0.2017 | 0.3311 | 0.2631 | 0.4086 | 0.4128 | 0.3369 | 0.3683 | 0.1627 | 0.1546 | 0.1749 | 0.2143 | 0.341 | 0.1682 |
| Nuclear Periphery | 0.003 | 0.0024 | 0.0012 | 0.0041 | 0.0012 | 0.0043 | 0.0046 | 0.0005 | 0.0021 | 0.0029 | 0.0008 | 0.0014 | 0.0028 | 0.0013 | 0.0048 | 0.0011 | 0.0016 | 0.0008 |
| Nucleolus | 0.0002 | 0.0001 | 0.0002 | 0.0001 | 0 | 0.0009 | 0.0003 | 0 | 0.0001 | 0.0106 | 0.0002 | 0.0001 | 0.0013 | 0.0001 | 0.0003 | 0 | 0.0001 | 0 |
| Nucleus | 0.0059 | 0.0038 | 0.0028 | 0.0093 | 0.003 | 0.0108 | 0.0051 | 0.0015 | 0.0035 | 0.0142 | 0.0019 | 0.0037 | 0.0042 | 0.0126 | 0.0149 | 0.0111 | 0.0089 | 0.0025 |
| Peroxisomes | 0.0011 | 0.0003 | 0.0003 | 0.0002 | 0.0001 | 0.0002 | 0.022 | 0.0005 | 0.0039 | 0.0039 | 0.0098 | 0.0075 | 0.0108 | 0.0003 | 0.0183 | 0.0001 | 0.0002 | 0.0195 |
| Punctate Nuclear | 0.0035 | 0.0004 | 0.0008 | 0.0009 | 0.0006 | 0.0075 | 0.0036 | 0.0007 | 0.0016 | 0.0035 | 0.0012 | 0.0024 | 0.0061 | 0.0015 | 0.0016 | 0.0005 | 0.0007 | 0.0029 |
| Vacuole | 0.0024 | 0.0016 | 0.0021 | 0.0021 | 0.0004 | 0.0018 | 0.0011 | 0.0004 | 0.0006 | 0.0025 | 0.0009 | 0.0005 | 0.0013 | 0.0008 | 0.001 | 0.0004 | 0.0009 | 0.0004 |
| Vacuole Periphery | 0.0003 | 0.0002 | 0.0002 | 0.0003 | 0.0001 | 0.0006 | 0.0004 | 0.0001 | 0.0002 | 0.0004 | 0.0003 | 0.0002 | 0.0002 | 0.0001 | 0.0003 | 0.0001 | 0.0002 | 0.0001 |
Sequencing Data
| R1 | R2 | |||||||||
|---|---|---|---|---|---|---|---|---|---|---|
| G1 Post-START | S/G2 | Metaphase | Anaphase | Telophase | G1 Post-START | S/G2 | Metaphase | Anaphase | Telophase | |
| Gene Expression | 27.0013 | 16.9615 | 17.9111 | 19.1444 | 20.8158 | 26.257 | 19.6233 | 24.708 | 25.6786 | 30.922 |
| Translational Efficiency | 0.845 | 0.6922 | 0.713 | 0.8343 | 0.786 | 0.9837 | 1.0283 | 0.7695 | 0.965 | 0.9817 |
Hit Data
| Dataset | Hit |
|---|---|
| Protein Concentration | ✘ |
| Protein Localization | ✘ |
| Gene Expression | ✘ |
| Translational Efficiency | ✘ |
Endocytosis
| Temp | Actin Patch (Sac6-tdTomato) | Cortical Patch (Sla1-GFP) | Late Endosome (Snf7-GFP) | Vacuole (Vph1-GFP) |
|---|---|---|---|---|
| 37℃ | ||||
| RT |
Cell Cycle Omics
CYCLoPs (Fdc1-GFP)
| Gene / Allele | Actin Patch (Sac6-tdTomato) | Cortical Patch (Sla1-GFP) | Late Endosome (Snf7-GFP) | Vacuole (Sac6-tdTomato) |
|---|
| Gene | Images |
|---|
| Gene | Images |
|---|
Images are not yet available
Images are not yet available